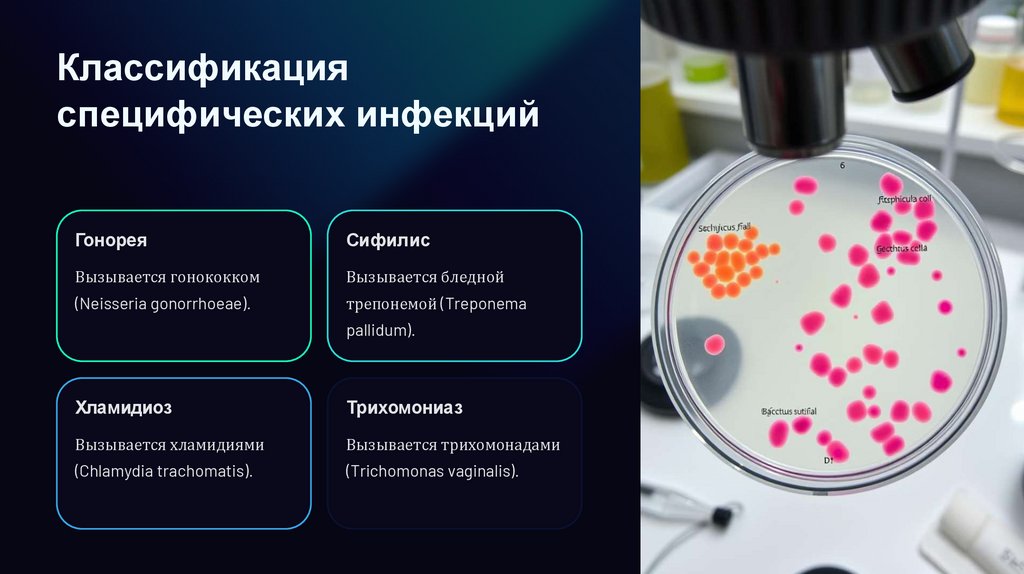

Similar presentations:
Воспалительные заболевания половых органов специфической этиологии
1.
Воспалительныезаболевания половых
органов специфической
Имя студента: Панахи Хашаяр
этиологии
6 группа 3 курс РУМ университет
Дата 19.01.2025
Этот доклад посвящен актуальной проблеме - воспалительным
заболеваниям половых органов (ВЗПО) специфической этиологии.
Мы рассмотрим основные возбудители, пути передачи,
клинические проявления, диагностику и методы лечения.
2.
В ведениеВ ажность ВДПО
Осложнения
Огромное значение в акушерстве.
Серьезные осложнения во время
беременности и после родов.
3.
ОпределениеИнфекции
Поражают половые органы у
женщин и мужчин.
Специфическая
этиология
Определённые возбудители:
хламидии, микоплазмы,
уреаплазмы.
4.
Основ ны е возбудител и и пути передачиВ озбудител и
Пути передачи
ВЗПО специфической этиологии вызваны
Основной путь передачи - половой, но возможны и
инфекционными агентами, такими как:
другие, включая:
Гонококк
Вертикальный (от матери к ребенку)
Бледная трепонема
Контактный (через предметы обихода)
Хламидии
Кровь (при переливании)
Трихомонады
5.
ЭтиологияХламидии
Микоплазмы
Chlamydia trachomatis - причина
Mycoplasma genitalium -
хламидиоза.
уретриты.
Уреаплазмы
Ureaplasma urealyticum - инфекции мочеполовой системы.
6.
Классификацияспецифических инфекций
Гонорея
Сифилис
Вызывается гонококком
Вызывается бледной
(Neisseria gonorrhoeae).
трепонемой (Treponema
pallidum).
Хламидиоз
Трихомониаз
Вызывается хламидиями
Вызывается трихомонадами
(Chlamydia trachomatis).
(Trichomonas vaginalis).
7.
Кл инические проявления идиагностика
Б ол ь
Выделения
Ощущение жжения, зуда,
Необычные выделения из
дискомфорта.
половых органов.
Воспаление
Диагностика
Покраснение, отечность,
Лабораторные анализы (мазок,
болезненность.
ПЦР).
8.
Гонорея: этиология,симптомы и осложнения
1
Этиология
2
Симптомы
Вызывается Neisseria
Гнойные выделения,
gonorrhoeae.
жжение при
мочеиспускании.
3
Осложнения
Бесплодие, воспаление органов малого таза.
9.
Сиф ил ис: стадии развития икл иническая картина
1
Первичная стадия
Появление твердого шанкра.
2
Вторичная стадия
Сыпь, лихорадка, увеличение лимфоузлов.
3
Третичная стадия
Поражение внутренних органов, нервной системы.
10.
Хламидиоз: особенности течения и последствияБессимптомное течение
1
Часто протекает без выраженных симптомов.
Воспаление мочеиспускательного канала
2
Жжение при мочеиспускании, выделения.
Воспаление органов малого таза
3
Боль внизу живота, проблемы с фертильностью.
Внематочная беременность
4
Серьезное осложнение, угрожающее жизни.
11.
Трихомониаз: характеристикавозбудителя и симптоматика
Возбудитель
Trichomonas vaginalis - одноклеточный паразит.
Симптомы
Пенистые выделения, зуд, жжение.
Диагностика
Микроскопическое исследование мазка.
12.
Принципы леченияспециф ических ВЗПО
1
2
Антибиотики
Противовирусные препараты
Назначаются в зависимости от
возбудителя.
При вирусных инфекциях
(например, герпес).
3
Иммунотерапия
Стимуляция иммунной системы.
13.
Эпидемиология В ДПОРост заболеваемости
Число случаев ВДПО, особенно у молодых женщин, демонстрирует
устойчивую тенденцию к росту. Это связано с изменением
сексуального поведения и недостаточной осведомленностью о
профилактике.
Группы риска
Женщины с большим количеством сексуальных партнеров и
женщины, посещающие несколько врачей, относятся к группам
риска. Регулярные обследования и использование презервативов
снижают вероятность заражения.
14.
Проф ил актика и меры предупрежденияБ езопасный секс
Регул ярные обследования
Здоровый образ жизни
Презервативы и другие методы
Своевременное выявление
Поддержание иммунитета и
барьерной контрацепции.
инфекций.
избегание факторов риска.
15.
Примеры клиническихслучаев
Кейс 1
Кейс 2
Женщина, 20 недель
Женщина после родов,
беременности, диагноз -
осложнение - послеродовой
хламидиоз. Назначено лечение
эндометрит, вызванный
антибиотиками для
хламидийной инфекцией.
предотвращения осложнений
Требуется длительная терапия
для матери и плода.
антибиотиками для полного
выздоровления.
16.
Заключение и дальнейшиедействия
1
Серьезная угроза
ВДПО представляют
2
Ответственность
врачей
серьезную угрозу женскому
Акушеры-гинекологи играют
здоровью, особенно во
ключевую роль в
время беременности и
профилактике, диагностике и
родов. Ранняя диагностика и
лечении ВДПО. Важно
лечение необходимы для
проводить регулярные
предотвращения
обследования и
осложнений.
консультирование
пациентов.

medicine
medicine








